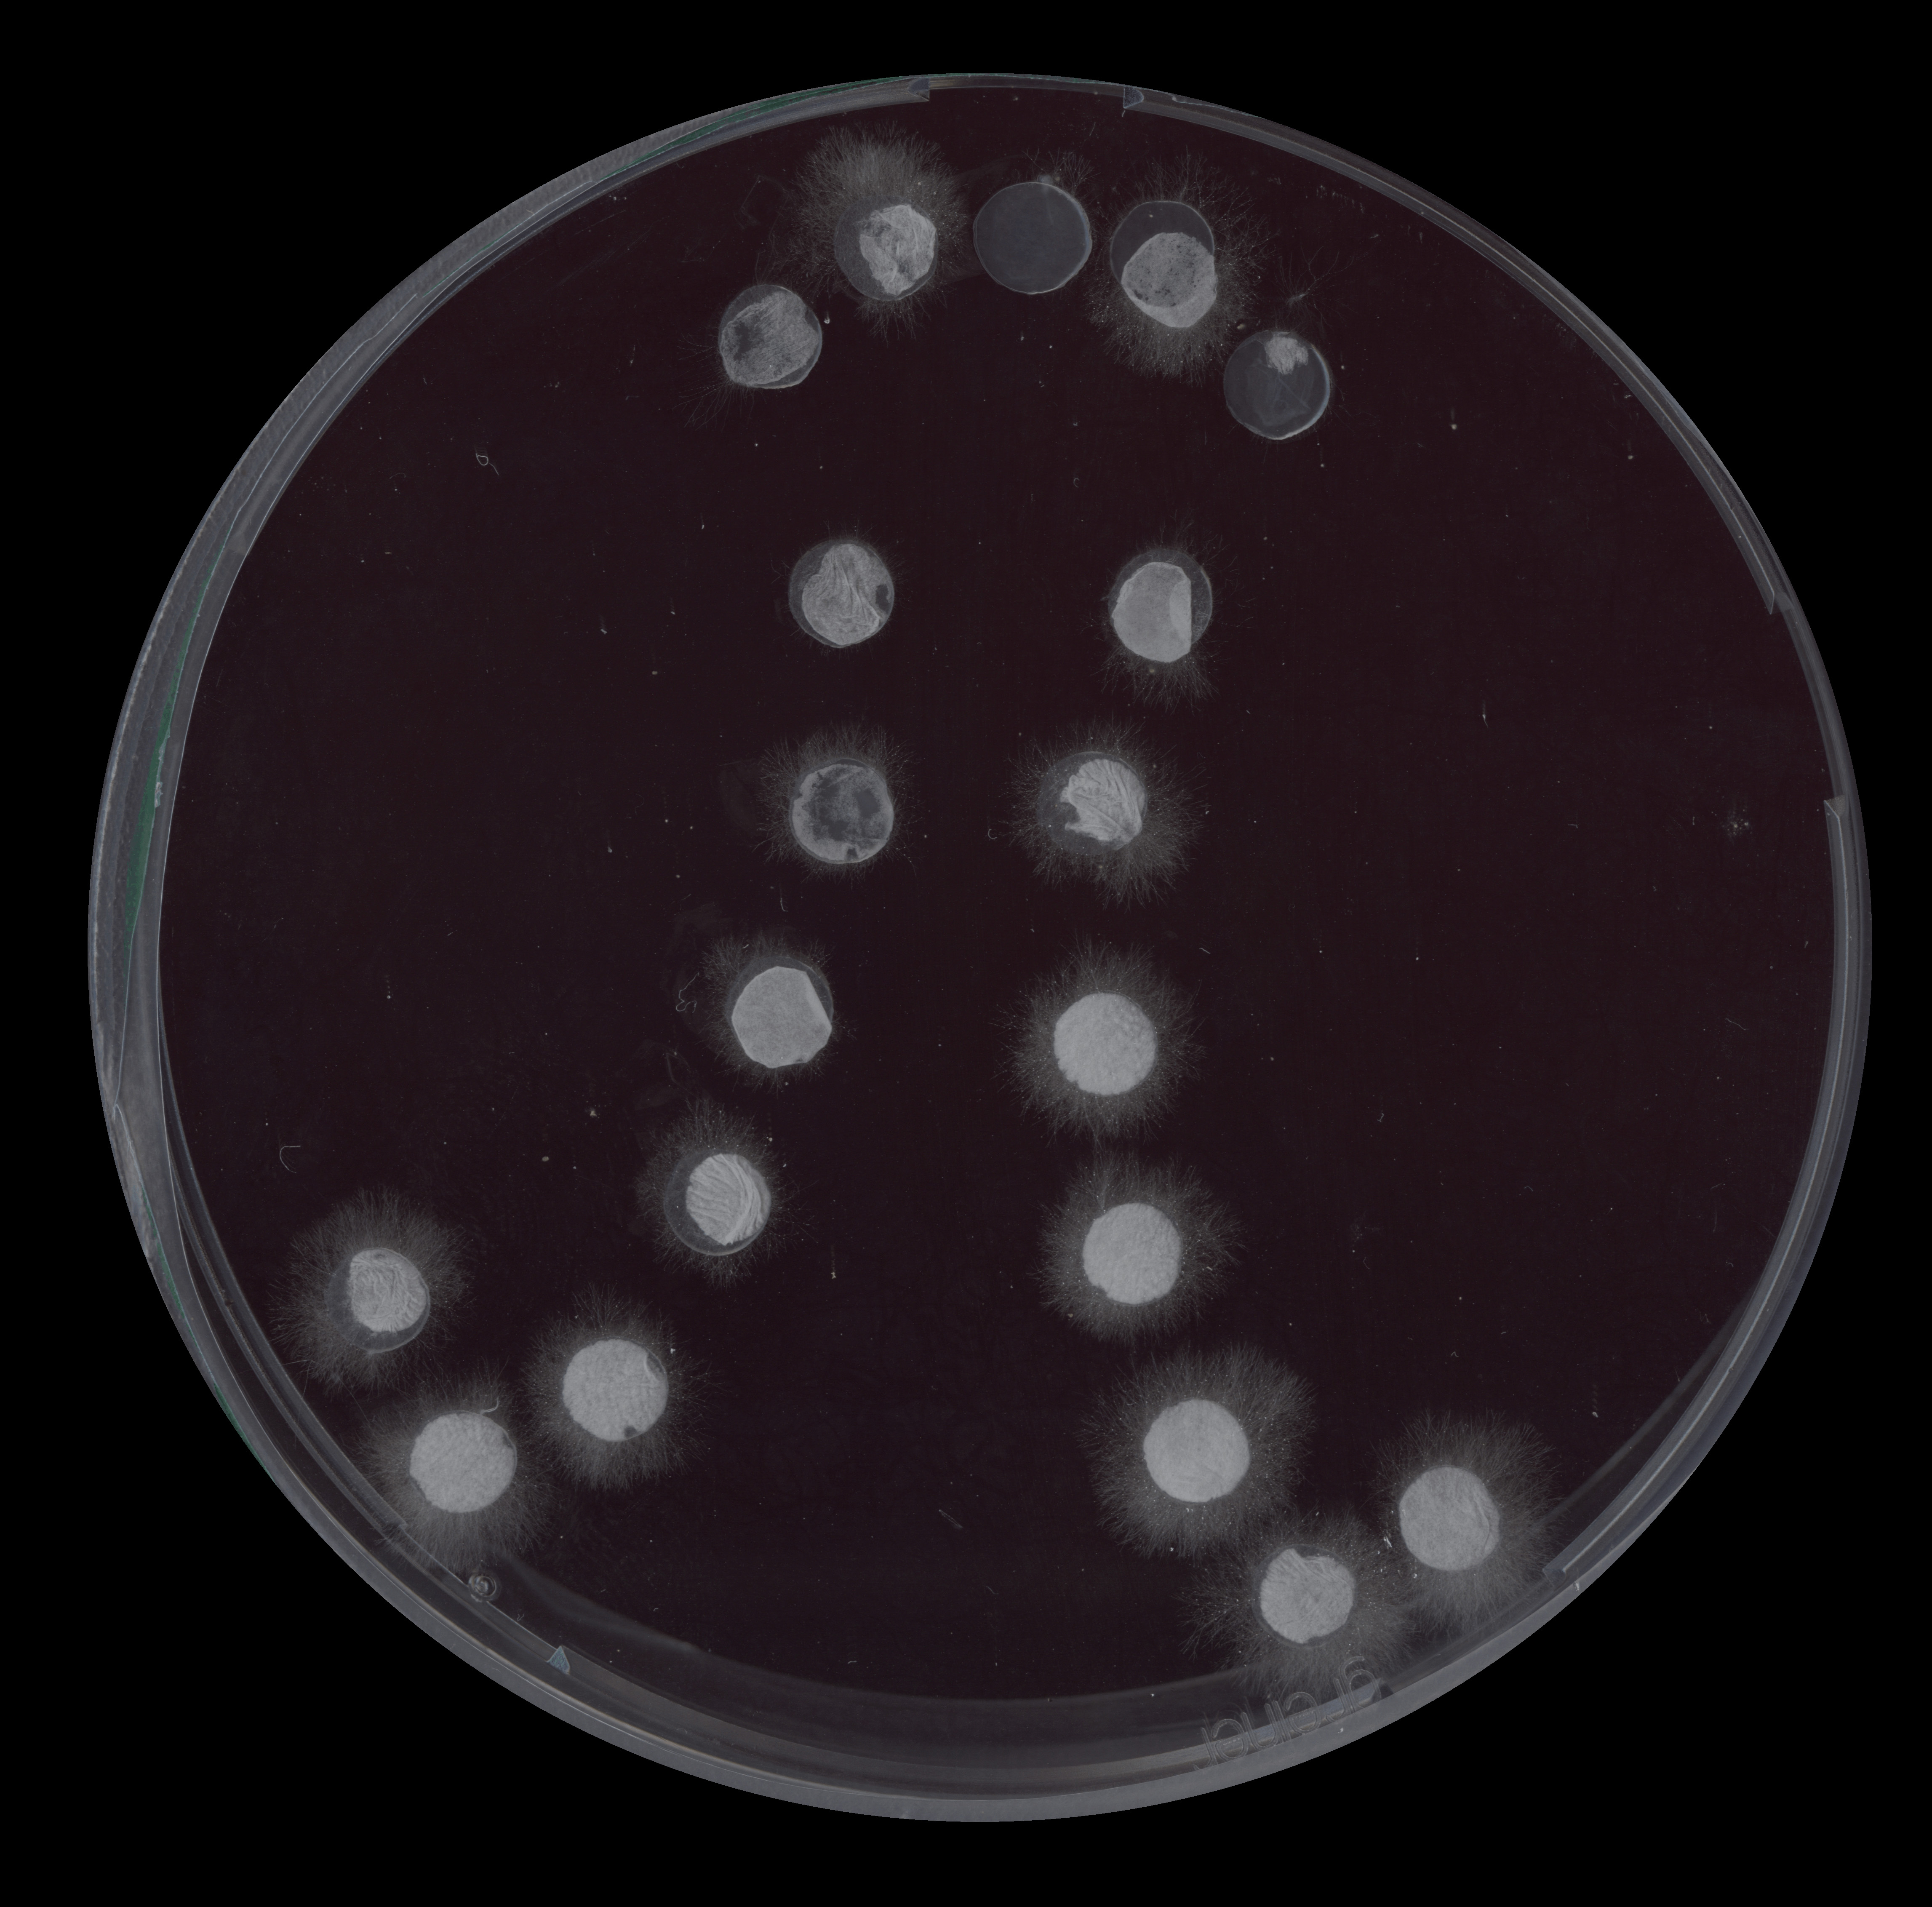

back to overview
Sofie Deckers ︎
Smakelijke vormen
grafische voorstellingen van verschillende maaltijden
-
graphic interpretations of various meals
![]()
Heike Dobbelaere ︎
Modulaire rugzak
modulaire rugzak samengesteld uit 6 vormen
-
modular backpack composed out of 6 shapes
![]()
![]()
Floor Smit ︎
reeks tekeningen gemaakt op een IPad Pro
-
series of drawings made on an IPad Pro
![]()
![]()
![]()
Fien Robbe ︎
lettertype samengesteld met de vormenbasis
-
font composed with the formbasis
![]()
vormen uit ribkarton, geschilderd met acrylverf
-
shapes out of cardboard, painted with acrylic paint
![]()
![]()
houten sculptuur
Dit werk is tijdens de S.M.A.K.H.A.C.K. actie (met een groep jonge kunstenaars werd een guerilla locker expo opgezet om zo een plaats op te eisen in het museum) gedoneerd aan het S.M.A.K. museum.
-
wooden sculpture This work has been donated to the S.M.A.K. museum during the the S.M.A.K.H.A.C.K. action (a group of young artist set up a guerilla locker exhibition in order to claim a spot in the museum).
![]()
![]()
![]()
![]()
Becky Snow ︎
print-ontwerpen voor textiel
-
print-designs for textiles
![]()
![]()
![]()
tegels uit beton
-
concrete tiles
![]()
![]()
Foam creatures
knutselactiviteit met kinderen van 6 tot 10 jaar
-
activity with 6 to 10 years old children
![]()
Leontien Allemeersch & Heike Dobbelaere ︎
ruimtelijke installatie in de glazen gang van het KASK - geïnspireerd op wegenwerken en wegsignalistaties
-
spatial installation in the glass corridor at KASK - inspired by construction works and road signs
![]()
![]()
![]()
![]()
Tor Ewen ︎
kleine sculpturen die knipogen naar prototypes voor 3D producten
-
small scale sculptures that hint at prototypes of 3D products
grafisch onderzoek naar de gelijkenissen van de vormenbasisvormen - digitaal en zeefdruk
-
graphic research on how the formbasisshapes relate to one another - digital and screenprint
![]()
![]()
Erik De Smedt ︎
![]()
Feralis Artwork ︎
Heike Dobbelaere ︎
vork en (koffie)lepeltje uit metaal
-
metal fork and (coffee) spoon
![]()
![]()
![]()
![]()
Liesbeth Eeckman ︎
digitale animatie over de transformatie van rups naar vlinder
-
digital animation about the transformation from caterpillar to butterfly
![]()
sticker composities in het straatbeeld
-
sticker composition in the cityscape
![]()
![]()
![]()
![]()
Various artists ︎
kleurplaten door kinderen van 3 tot 9 jaar
-
coloring pages by 3 to 9 years old children
![]()
![]()
![]()
![]()
![]()
![]()
![]()
![]()
Dominique De Groen ︎
gedicht geïnspireerd door de boog-vorm
-
poem inspired by the bow-shape
![]()
Trui De Smet ︎
Opberger
opbergtas met zijzakken
-
storage bag with side pockets
![]()
![]()
Itamar Vigdorovich ︎
Tessellations
vormen herhaald volgens een wiskundige principe
-
shapes repeated according to a mathematical principle
![]()
![]()
![]()
![]()
collage met zijde papier
-
collage with silk paper
![]()
Liselotte Deligne ︎
schimmelgroei op petrischaaltje
-
fungi growth on a petri dish
![]()
![]()
![]()
![]()
Danny Dobbelaere ︎
vorm plat vorm note book
notebooks
![]()
![]()
Nick Mattan ︎
overlappende vormen
-
overlapping shapes
![]()
![]()
Woordvormen
workshop waarbij studenten een woord en definitie moesten verzinnen bij een bepaalde vorm
-
workshop in which students had to invent a word and definitaion after a shape
![]()
Heike Dobbelaere ︎
naamkaartjes voor het vormplatvorm
-
business cards for the formflatform
![]()
![]()
Vormenfitness
collage en tekening en papier
-
collage and drawings
![]()
Henri De Veene ︎
digitale tekening
-
digital drawing
![]()
Smakelijke vormen
grafische voorstellingen van verschillende maaltijden
-
graphic interpretations of various meals

Heike Dobbelaere ︎
Modulaire rugzak
modulaire rugzak samengesteld uit 6 vormen
-
modular backpack composed out of 6 shapes


Floor Smit ︎
Bikini ladies
reeks tekeningen gemaakt op een IPad Pro
-
series of drawings made on an IPad Pro



Fien Robbe ︎
Lettervorm
lettertype samengesteld met de vormenbasis
-
font composed with the formbasis

Sara Du Pont ︎
Verruimende Vormen
vormen uit ribkarton, geschilderd met acrylverf
-
shapes out of cardboard, painted with acrylic paint


Heike Dobbelaere ︎
Vormpuzzel
houten sculptuur
Dit werk is tijdens de S.M.A.K.H.A.C.K. actie (met een groep jonge kunstenaars werd een guerilla locker expo opgezet om zo een plaats op te eisen in het museum) gedoneerd aan het S.M.A.K. museum.
-
wooden sculpture This work has been donated to the S.M.A.K. museum during the the S.M.A.K.H.A.C.K. action (a group of young artist set up a guerilla locker exhibition in order to claim a spot in the museum).




Becky Snow ︎
Linked Prints
print-ontwerpen voor textiel
-
print-designs for textiles



Janne Claes ︎
Concrete Objectstegels uit beton
-
concrete tiles


Leerlingen van De Sterrespits ︎
Foam creaturesknutselactiviteit met kinderen van 6 tot 10 jaar
-
activity with 6 to 10 years old children

Leontien Allemeersch & Heike Dobbelaere ︎
MAP#76 - Construction Zone
ruimtelijke installatie in de glazen gang van het KASK - geïnspireerd op wegenwerken en wegsignalistaties
-
spatial installation in the glass corridor at KASK - inspired by construction works and road signs




Tor Ewen ︎
Shapesculptures
kleine sculpturen die knipogen naar prototypes voor 3D producten
-
small scale sculptures that hint at prototypes of 3D products




Heike Dobbelaere ︎
Vormverstandhoudingen
grafisch onderzoek naar de gelijkenissen van de vormenbasisvormen - digitaal en zeefdruk
-
graphic research on how the formbasisshapes relate to one another - digital and screenprint


Erik De Smedt ︎
Sirenenlied
gedicht geïnspireerd op een 30-tal vormen
-
poem inspired by approximately 30 shapes

Feralis Artwork ︎
Haakje
tattoo
Heike Dobbelaere ︎
Cutlery
vork en (koffie)lepeltje uit metaal
-
metal fork and (coffee) spoon




Liesbeth Eeckman ︎
Vlinder
digitale animatie over de transformatie van rups naar vlinder
-
digital animation about the transformation from caterpillar to butterfly

Robbert&Frank Frank&Robbert ︎
Urbanstickerinterventions
sticker composities in het straatbeeld
-
sticker composition in the cityscape




Various artists ︎
Kleurplaten - coloring pages
kleurplaten door kinderen van 3 tot 9 jaar
-
coloring pages by 3 to 9 years old children








Dominique De Groen ︎
Laagland
gedicht geïnspireerd door de boog-vorm
-
poem inspired by the bow-shape

Trui De Smet ︎
Opberger
opbergtas met zijzakken
-
storage bag with side pockets


Itamar Vigdorovich ︎
Tessellations
vormen herhaald volgens een wiskundige principe
-
shapes repeated according to a mathematical principle




Aubry Dermine ︎
Boeket Bloemencollage met zijde papier
-
collage with silk paper

Liselotte Deligne ︎
Fungul Art
schimmelgroei op petrischaaltje
-
fungi growth on a petri dish

Danny Dobbelaere ︎
vorm plat vorm note booknotebooks


Nick Mattan ︎
Schier
overlappende vormen
-
overlapping shapes


Sociaal Werk Studenten Hogent ︎
Woordvormen
workshop waarbij studenten een woord en definitie moesten verzinnen bij een bepaalde vorm
-
workshop in which students had to invent a word and definitaion after a shape

Heike Dobbelaere ︎
Puzzle
naamkaartjes voor het vormplatvorm
-
business cards for the formflatform


Tineke Vandenabeele ︎
Vormenfitness
collage en tekening en papier
-
collage and drawings

Henri De Veene ︎
Eddie
digitale tekening
-
digital drawing



